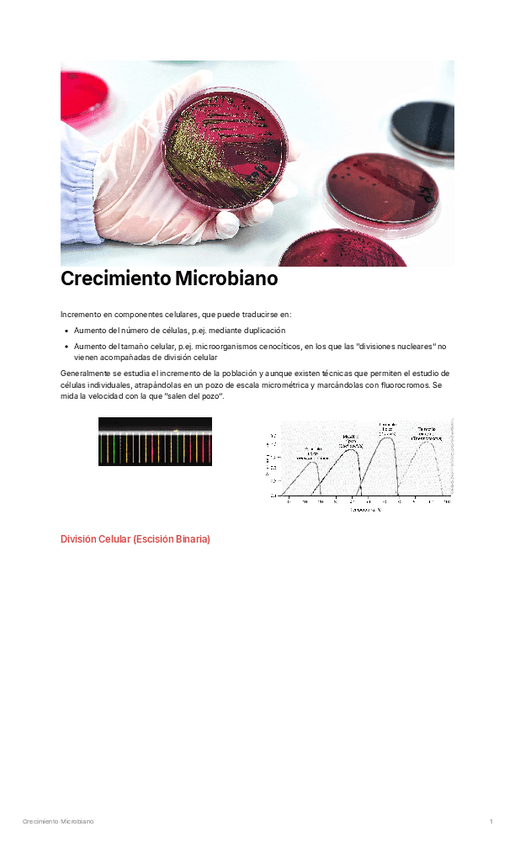

Microbiología
apuntes
-
Parcial 2- Micro
He publicado nuevos apuntes de 2º Microbiología: Parcial 2- Micro
apuntes
-
Tema 0- Origen y extensión
He publicado nuevos apuntes de 2º Microbiología: Tema 0- Origen y extensión
apuntes
-
Temario completo microbiología
He publicado nuevos apuntes de 2º Microbiología: Temario completo microbiología
He publicado nuevos apuntes de 2º Microbiología: microbiologia-2o-parte.pdf
He publicado nuevos ejercicios de 2º Microbiología: Problemas-de-crecimiento.pdf
He publicado nuevos ejercicios de 2º Microbiología: ejercicio-microbiologia.pdf
apuntes
-
Temas 1-8
He publicado nuevos apuntes de 2º Microbiología: Temas 1-8
He publicado nuevos apuntes de 2º Microbiología: mapa-conceptual-GENETICA-BACTERIANA.pdf
He publicado nuevos apuntes de 2º Microbiología: apuntes-extra-MICRO.pdf
He publicado nuevos apuntes de 2º Microbiología: Resumen-proteobacterias.pdf
He publicado nuevos apuntes de 2º Microbiología: Mapa-conceptual-5-CRECIMIENTO-MICROBIANO.pdf
He publicado nuevos apuntes de 2º Microbiología: MICROBIOLOGIA-tema-5.pdf
He publicado nuevos apuntes de 2º Microbiología: PRACTICAS-MICROBIOLOGIA.pdf
He publicado nuevos apuntes de 2º Microbiología: MAPA-CONCEPTUAL-CULTIVO-DE-MICROORGANISMOS.pdf
ejercicios
-
Entregas evaluación continua
He publicado nuevos ejercicios de 2º Microbiología: Entregas evaluación continua
apuntes
-
Apuntes completos
Curso 2024-2025
ejercicios
-
EVALUACIÓN CONTINUA
Curso 2024-2025
apuntes
-
ENTREGAS
He publicado nuevos apuntes de 2º Microbiología: ENTREGAS
He publicado nuevos apuntes de 2º Microbiología: Tabla-Bacterias-Practicas.pdf
He publicado nuevos apuntes de 2º Microbiología: apuntes-1o-parcial.docx
apuntes
-
APUNTES MICRO
He publicado nuevos apuntes de 2º Microbiología: APUNTES MICRO
He publicado nuevos apuntes de 2º Microbiología: BACTERIA-PROBLEMA.-SALMONELLA.pdf
He publicado nuevos apuntes de 2º Microbiología: resumen-practicas-micro.pdf
trabajos
-
Problemas microbiología
He publicado nuevos trabajos de 2º Microbiología: Problemas microbiología
He publicado nuevos apuntes de 2º Microbiología: Cuadro-resumen-bacterias-practicas.pdf
apuntes
-
microbiologia y parasitología
He publicado nuevos apuntes de 2º Microbiología: microbiologia y parasitología

¡Estás al día!
Has visto todos los archivos